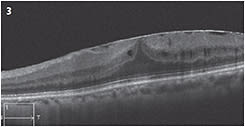

Focus on Retina
A close look at ocriplasmin for VMI disease
The use of this recombinant protease requires an appreciation for the history of VMI.
By Nora W. Muakkassa MD and Michelle C. Liang MD
Ocriplasmin, marketed under the name Jetrea (ThromboGenics Inc., Iselin, N.J.), is the first FDA-approved drug for the treatment of diseases of the vitreomacular interface (VMI). The 2012 approval of ocriplasmin, along with the increasing use and ever-improving resolution of OCT, has ushered in a new era of focus on diseases of the VMI.
As the body ages, the vitreous liquefies and adhesions of the vitreoretinal interface weaken. Together, these events typically result in a posterior vitreous detachment (PVD). However, sometimes this process does not occur so smoothly. This anomalous PVD consequently results in diseases of the VMI. While vitreomacular adhesion is considered a normal part of aging, vitreomacular traction (VMT), epiretinal membrane (ERM), lamellar hole and full-thickness macular hole (FTMH) can result from an anomalous PVD.
This article details the current understanding of diseases of the VMI, treatment options, and the best candidates for treatment with ocriplasmin.
CLASSIFYING VMI DISEASES
OCT imaging
OCT has become increasingly useful in characterizing diseases of the VMI. With OCT we can visualize the vitreomacular interface, detect mild epiretinal membranes, distinguish between lamellar holes and full-thickness macular holes, and measure the size of macular holes. Due to this change in clinical practice, an OCT-based classification scheme was developed by the International Vitreomacular Traction Study (IVTS) Group in 2012 which proposed anatomic definitions of the following diseases:1
• Vitreomacular adhesion (VMA).
• Vitreomacular traction (VMT).
• Epiretinal membrane (ERM).
• Lamellar hole.
• Full-thickness macular hole (FTMH).
Diseases of the VMI
The IVTS defined VMA as vitreous attachment to the macula with adjacent separation of the vitreous from the retinal surface without distortion of the retinal anatomy1 (Figure 1). VMT is defined as VMA with resultant distortion of the retinal architecture, which can include intraretinal cysts, distortion of the foveal anatomy or focal neurosensory foveal detachment (Figure 2). VMA and VMT can either be focal (1,500 µm or smaller) or broad (larger than 1,500 µm).

Figure 1: This OCT image shows broad VMA. Note the normal foveal architecture. Arrows highlight the posterior vitreous cortex.

Figure 2: OCT shows focal VMT with intraretinal cysts; arrows highlight the posterior vitreous cortex.
An ERM is thought to occur in the setting of vitreoschisis, which itself can occur secondary to an anomalous posterior vitreous detachment that involves “splitting” of the vitreous and some posterior vitreous remaining on the surface of the retina. This posterior vitreous acts as a scaffold for glial cells to proliferate and form an ERM (Figure 3). These membranes may not cause any visual symptoms — or they may cause metamorphopsia or blurred vision due to macular traction and retinal thickening.
Figure 3: OCT shows an epiretinal membrane with distortion of foveal anatomy and small intraretinal cysts with absence of VMA.
Lamellar holes or partial-thickness macular holes can appear similar to full-thickness macular holes on slit lamp biomicroscopy. OCT imaging of lamellar holes may show an irregular foveal contour or loss of the inner retina, or both, but an intact photoreceptor layer is always present (Figure 4). FTMHs are defined as an absence of all retinal layers in the foveal region (Figure 5, page 40). They can be small (250 µm or smaller), medium (250 µm to 400 µm) or large (400 µm or larger).

Figure 4: This lamellar hole without VMA shows an abnormal foveal contour, but an intact photo-receptor layer.

Figure 5: OCT shows a small FTMH (225 µm) with focal VMT. The posterior vitreous cortex (arrows) and aperture at which the width of the macular hole is measured (double arrowhead) are visible.
PHARMACOLOGIC VITREOLYSIS
Vitreoretinal surgery
Before the FDA approved ocriplasmin in 2012, the only treatment options for diseases of the VMI were observation or vitreoretinal surgery. The visual outcomes of vitrectomy with membrane peel for ERM or macular holes are favorable; however, no surgery is without risk. The high rate of cataract formation and the fear of serious complications related to surgery make the prospect of medical treatment appealing both to patients and physicians.
Time for a change
Donald Gass, MD, proposed a staging system for macular holes in 1988 that has been widely used for the past 25 years. Until recently, this was the only universally accepted classification scheme for diseases of the VMI. Newer imaging modalities and treatments for diseases of the VMI warranted an updated classification scheme by the IVTS in 2012.
Mechanism of action
Ocriplasmin is a recombinant protease the FDA approved for the treatment of “symptomatic VMA.” The phase 3 trials defined this term as vitreous adhesion within the central 6 mm of the macula with adjacent separation of the posterior cortex from the retina, and visual acuity worse than 20/25.2
Through pharmacologic vitreolysis, ocriplasmin is designed to cleave proteins of the vitreoretinal interface, resulting in weakening and release of VMA, according to ThromboGenics. It is administered as an intravitreal injection (0.125 µg/0.1mL) that can be given in the office.
MIVI-TRUST findings
The MIVI-TRUST study group analyzed the results of two phase 3 randomized, double-blind, placebo-controlled trials that led to the FDA-approval of ocriplasmin. The study enrolled 652 eyes with symptomatic VMA. Eyes were randomized to receive either 0.125 µg of ocriplasmin in 0.1mL of drug vehicle or an intravitreal injection of 0.1mL of the drug vehicle.
The study endpoint was release of the VMA, not visual acuity or even closure of a macular hole, if present. By day 28, 26.5% of the ocriplasmin-injected eyes experienced release of VMA vs. 10.1% of placebo eyes. The rate of closure of FTMH was 40.6% in the study eyes vs. 10.6% in the placebo group. No holes larger than 400 µm closed in either group.2
Based on the study endpoints, a case with release of VMA but subsequent formation or persistence of a FTMH was classified a “success,” although neither the patient nor ophthalmologist would deem this outcome a success.
VMA with concurrent macular disease
The MIVI-TRUST study group data have suggested that patients with VMA and ERM do not respond as well to ocriplasmin as those without ERM. Even in cases of successful release of VMA, these patients may be more likely to require vitrectomy in the long run for macular traction secondary to the ERM rather than the VMT.
The effectiveness of ocriplasmin in patients with concurrent macular disease, such as diabetic macular edema or exudative age-related macular degeneration, has not yet been determined. In some instances, it can be difficult to determine whether the retinal disease or vitreomacular disease is causing a patient’s symptoms. Clinicians should take this into consideration before making a decision to treat.
On further evaluation of the results, the study found that release of VMA was more likely in phakic patients as compared with pseudophakic patients, those with focal rather than broad VMA and those without ERM.3,4 The most common adverse events in the study were floaters and photopsias in 16.8% and 11.8% of patients, respectively. Approximately 9% of patients complained of blurred vision and 5% complained of visual impairment.
ADMINISTERING OCRIPLASMIN
Appropriate candidates
The patient must have VMA before ocriplasmin is indicated. Patients with diseases of the VMI, such as ERM or FTMH, without VMA would not benefit from ocriplasmin. In patients diagnosed with “symptomatic VMA,” the clinical trial data have suggested that patients with the following characteristics are more likely to respond to ocriplasmin:
• Phakic lens status.
• Age 65 years or younger.
• Focal, rather than broad, VMA.
• No associated ERM.
• Full-thickness macular hole smaller than 400 µm wide.
Additionally, small FTMHs (up to 250 µm) are more likely to respond than medium size FTMHs.4 If a physician decides to treat with ocriplasmin, an OCT should be obtained on the day of scheduled treatment to assess for spontaneous release of VMA before treatment.
Additional factors to consider
VMA in and of itself is a normal finding and is asymptomatic. It is impossible, however, to predict whether VMA will release spontaneously without consequence or whether it will progress to VMT with or without a FTMH. Typically, we have no indication to treat patients with asymptomatic VMA.
Additionally, use of ocriplasmin in patients with macular holes without VMT is futile because there is no adhesion to release. Even in cases of definite VMT, no cases of closure of FTMH larger than 400 µm with ocriplasmin have been reported. Observation or surgery is the only treatment option for these patients.
POTENTIAL COMPLICATIONS
Ellipsoid zone loss and subretinal fluid
One retrospective study of 17 patients treated with ocriplasmin for symptomatic VMA found a response rate of 47.1%, compared with 26.5% in the MIVI-TRUST trials.5 The investigators attributed this higher success rate to better patient selection. The patients enrolled in the study tended to have more positive predictors of successful response based on the phase 3 trials: age younger than 65 years, phakic lens status, absence of ERM and focal VMA.
The authors also reported a significant proportion of patients with transient subretinal fluid or loss of the ellipsoid zone of the outer retina after treatment, or both. Of the seven patients with transient loss of the ellipsoid zone, six had successful release of VMA. The average time to loss and return of the ellipsoid zone was five days and 29.3 days, respectively. Similarly, the occurrence and resolution of subretinal fluid occurred at an average of 4.8 days and 30 days after injection, respectively. In all cases, the subretinal fluid resolved and the ellipsoid zone reappeared. The long-term effects of these findings are unclear.5
Abnormal electroretinograms
A few more recent case reports have described abnormal electroretinogram (ERG) findings after treatment with ocriplasmin. One report from Tufts Medical Center described a patient who underwent treatment with ocriplasmin for symptomatic VMT with a visual acuity of 20/60.6
The next day, this patient’s visual acuity was 20/200 and she complained of darkening of her vision. Spectral-domain OCT (SD-OCT) showed successful release of the VMA, but also disruption of the ellipsoid zone. At four months, she continued to complain of darkening of her vision and ERG demonstrated reduced a- and b-wave amplitudes.6
Another report from the University of Michigan described a similar case in a 63-year-old woman with a small FTMH associated with VMA and a visual acuity of 20/40.7 Nine days after injection with ocriplasmin, the FTMH had enlarged, her visual acuity had worsened to 20/125 and visual field testing demonstrated generalized constriction. Similar to the case described previously, SD-OCT demonstrated abnormalities in the outer retina and ERG testing revealed rod and cone dysfunction.7
These outer retinal abnormalities and ERG changes are likely the cause of anecdotal visual disturbances many patients reported in the initial trials after receiving an injection of ocriplasmin. Authors have proposed from these post-clinical trial case reports that these outer retinal changes may be due to a diffuse toxicity of ocriplasmin to the photoreceptors or retinal pigment epithelium, or both.5-8 More research is needed to elucidate the exact cause and long-term effects of this retinal toxicity in patients undergoing treatment with ocriplasmin.
Potential of ocriplasmin
Ocriplasmin can be an effective non-surgical treatment option for patients with symptomatic VMA. However, we have observed unexpected post-injection findings and both patients and clinicians should be aware of these potential complications when discussing their options.
With increased use of ocriplasmin in clinical practice, retina specialists continue to gather more data to help determine the best candidates for treatment. This novel, non-surgical treatment option is an appealing alternative to surgery when used in the right patient, and continued studies will help us identify these patients. OM
REFERENCES
1. Duker JS, Kaiser PK, Binder S, et al. The international vitreomacular traction study group classification of vitreomacular adhesion, traction and macular hole. Ophthalmol. 2013;120:2611-2619.
2. Stalmans P, Benz MS, Gandorfer A, et al. MIVI-TRUST study group. Enzymatic vitreolysis with ocriplasmin for vitreomacular traction and macular holes. New Engl J Med. 2012;367:606-615.
3. Kaiser PK. Medical management with pharmacologic agents: rationale and clinical trials. Paper presented at: Contemporary Management of Diseases of the Vitreomacular Interface; Boston, MA; July 13, 2013.
4. Regillo CD. Ocriplasmin in clinical practice: how and when to use it. Paper presented at: Contemporary Management of Diseases of the Vitreomacular Interface; Boston, MA; July 13, 2013
5. Singh RP, Li A, Bedi R, et al. Anatomical and visual outcomes following ocriplasmin treatment for symptomatic vitreomacular traction syndrome. Br J Ophthalmol. Published Online First: [December 19, 2013] doi.10.1136/bjophthalmol-2013-304219
6. Tibbetts MD, Reichel E, Witkin AJ. Vision loss after intravitreal ocriplasmin: correlation of spectral-domain optical coherence tomography and electroretinography. JAMA Ophthalmology. 2014;132:487-490.
7. Fahim AT, Khan NW, Johnson MW. Acute panretinal structural and functional abnormalities after intravitreous ocriplasmin injection. JAMA Ophthalmol. 2014;132:484-486.
8. Freund KB, Shah SA, Shah VP. Correlation of transient vision loss with outer retinal disruption following intravitreal ocriplasmin. Eye. 2013;27:773-774.
RESOURCES
1. Gass JDM. Idiopathic senile macular hole: its early stages and pathogenesis. Arch Ophthalmol. 1988;106:629-639.
2. Kim BT, Schwartz SG, Smiddy WE, et al. Initial outcomes following intravitreal ocriplasmin for treatment of symptomatic vitreomacular adhesion. Ophthal Surg Las IM Ret. 2013;44:334-343.
3. Chan A, Duker JS, Schuman JS, Fujimoto JG. Stage 0 Macular Holes: Observations by optical coherence tomography. Ophthalmol. 2004;111:2027-2032.
About the Authors | |

| Nora W. Muakkassa, MD, is an ophthalmology resident at Tufts Medical Center/New England Eye Center in Boston. |

| Michelle C. Liang, MD, is a vitreoretinal fellow at the New England Eye Center and Ophthalmic Consultants of Boston and a clinical associate at Tufts University School of Medicine. |
Disclosures: Drs. Muakkassa and Liang have no conflicts to disclose. | |








